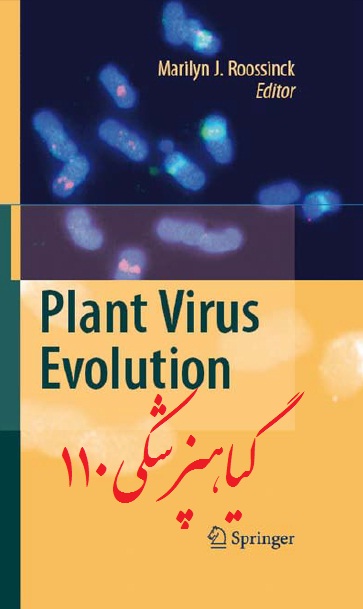

دانلود پاورپوینت زیبا در مورد فاکتورهاي مهم در تشخيص ميزبان توسط قارچ هاي ميکوريز داخلي
دانلود پاورپوینت فارسی زیبا در مورد فاکتورهاي مهم در تشخيص ميزبان توسط قارچ هاي ميکوريز داخلي


برای دانلود فایل مورد نظر بر رو ی ادامه مطلب کلیک کنید
دانلود پاورپوینت فارسی زیبا در مورد فاکتورهاي مهم در تشخيص ميزبان توسط قارچ هاي ميکوريز داخلي


برای دانلود فایل مورد نظر بر رو ی ادامه مطلب کلیک کنید
دانلود کتاب تکامل ویروس های گیاهی
(Plant Virus Evolution)

برای دانلود فایل مورد نظر بر روی ادامه مطلب کلیک کنید
دانلود کلیپ زیبا در مورد بیماری های درختان سیب


برای دانلود فایل مورد نظر بر روی ادامه مطلب کلیک کنید
دانلود کتاب میکوریزای آربسکولار:
فیزیولوژی و نقش آن
(Arbuscular Mycorrhizas: Physiology and Function)


برای دانلود فایل مورد نظر بر روی ادامه مطلب کلیک کنید
دانلود کتابچه فارسی حفاظت درختان مرکبات در برابر سرما و يخبندان
دانلود پاورپوینت فارسی زیبا در مورد معرفي بيماري شناسي گياهي
دانلود کتاب اطلس کاربردی برای تشخیص باکتری ها
(Practical Atlas for Bacterial Identification )
دانلود کتاب بیولوژی آفات گیاهی
(Insect Plant Biology)
دانلود کتابچه فارسی نگاهي بر اثرات سرما بر محصولات زراعي و باغي کشور در سال 89


برای دانلود فایل مورد نظر بر روی ادامه مطلب کلیک کنید